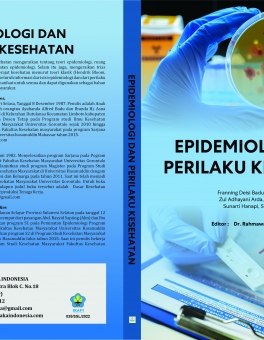

● online
- PARADIGMA KINERJA TENAGA PENDIDIK....
- KEPERAWATAN ANAK (MASALAH KESEHATAN PADA ANAK DENG....
- PEMBERDAYAAN DIRI DAN KUALITAS HIDUP PENDERITA DIA....
- STRATEGI DAN OPTIMASI PENINGKATAN KINERJA GURU....
- KEPERAWATAN KRITIS (CRITICAL NURSING )....
- Histeroskopi Diagnostik (PARADIGMA BARU DALAM BEDA....
- HOME CARE NURSING....
- KUALITAS PEMBELAJARAN DAN KESIAPAN KERJA LULUSAN P....
| Stok | Tersedia |
| Kategori | BOOK |
JUDUL :
PEMBERDAYAAN DIRI DAN KUALITAS HIDUP PENDERITA DIABETES MELLITUS TIPE 2
PENULIS :
Dr. Sri Syatriani, SKM., M.Kes.
HALAMAN : viii + 101
ISBN :978-634-7107-33-6
DESKRIPSI BUKU
Buku ini berisi materi tentang diabetes mellitus, pengelolaan penyakit diabetes mellitus, pemberdayaan diri penderita diabetes mellitus, dan hubungan pemberdayaan diri dengan kualitas hidup penderita diabtes mellitus. Sebagai referensi bacaan bagi penderita diabetes mellitus untuk mengembangkan kemampuan diri dan memberdayakan diri mereka dalam pengelolaan penyakitnya sehingga penderita diabetes mellitus tetap produktif dan meningkatkan kualitas hidup penderita. Penulis berharap buku ini dapat menambah pengetahuan dan wawasan masyarakat khususnya penderita diabetes mellitus dan mahasiswa kesehatan. Selain itu, penulis juga berharap buku ini dapat menambah perbendaharaan referensi atau sumber pustaka diabetes mellitus.
| Dilihat | 144 kali |
| Diskusi | Belum ada komentar |
JUDUL : EPIDEMIOLOGI DAN PERILAKU KESEHATAN PENULIS : FRANNING DEISI BADU, SKM., M.Kes ZUL ADHAYANI ARDA, SKM., M.Kes SUNARTI HANAPI, SKM., M.Kes HALAMAN : vi + 133 ISBN : 978-623-8050-63-5 DESKRIPSI BUKU Buku Berjudul : Epidemiologi dan Perilaku kesehatan menguraikan tentang teori epidemiologi, ruang lingkup, definisi, sejarah, manfaat dan pendekatan epidemiologi. Selain itu juga,… selengkapnya
Rp 70.000 Rp 85.000JUDUL :BUKU AJAR EKOLOGI KEPULAUAN (Terintegrasi Pendidikan Karakter Kebangsaan) KEPENGARANGAN Prof. Dr. Abdulrasyid Tolangara, M.Si Dr. Bahtiar, M.Si Dr. M. Nasir Tamalene, M.Pd Dr. Zulkifli Zamzam, M.Sc Dr. Andi Tenri Pada Agustang, S.Sos., M.Pd. Zulkifli Ahmad, S.Pd, M.Sc Nuraini Siradjudin, S.Pd, M.Si ISBN : 978-623-8050-04-8 tebal : 460 Halaman DESRIPSI BUKU : Buku ini… selengkapnya
Rp 239.000 Rp 250.000JUDUL : STRATEGI PENINGKATAN PRODUKTIVITAS DOSEN MENYONGSONG INDONESIA EMAS 2045 PENULIS : Achmad Fauzi, SS., S.Pd.I., M.Pd Prof. Dr. Ing. Soewarto Hardhienata Dr. H. Oding Sunardi, M.Pd HALAMAN : vii + 165 ISBN : 978-623-8050-80-2 DESKRIPSI BUKU Dosen sebagai pendidik akan menemukan masalah-masalah baru dalam menjalankan tugas dan tantangannya dimasa kini dan masa akan… selengkapnya
Rp 75.000 Rp 85.000JUDUL :PEMBIAYAAN MURĀBAḤAH, IJĀRAH DAN KESEJAHTERAAN NASABAH PENULIS : ATIN MUFIDAH Ukuran unesco (15,5 x 23 cm ) Halaman : vi + 60 Isbn : 978-623-8050-42-0 DESKRIPSI BUKU Pembiayaan murābaḥah merupakan akad pembiayaan yang diterapkan melalui jual beli dengan… selengkapnya
Rp 90.000 Rp 100.000JUDUL : ILMU BIOMEDIK DASAR KEPENGARANGAN : Dr. apt. Muntasir. S.Si., M.Si apt. Andi Ifriany Harun, S.Si. M.Si Dr. Ns. Makkasau, M.Kes., M.EDM Sugiyarto, SST., Ners., M.Kes Nurul Hidayah, S.Kep., Ns, M.Kep Supriliyah Praningsih S.Kep., Ns., M.Kep Ns.Sinta Wijayanti,M.Kep, Sp.Kep,MB Ns. Sri Melfa Damanik, M.Kep., Sp.Kep.An Ns Rusmala Dewi,M.Kep,Sp.Kep.Mat Kadek Yuke Widyantari, S.SiT., M.Keb. Ukuran… selengkapnya
Rp 239.000 Rp 250.000JUDUL : KEPERAWATAN KESEHATAN JIWA DAN PSIKOSOSIAL PENULIS Ns. Sri Nyumirah, M.Kep., Sp.Kep.J Kens Napolion, S.Kp., M.Kep., Sp.Kep.J Ns. Fifi alviana, MSN. Basmalah Harun, S.Kep., M.Kes. Ns. Balbina Antonelda Marled Wawo, M.Kep., Sp.Kep.J S. Dwi Sulisetyawati, S.Kep., Ns., M.Kep. Iin Aini Isnawati, S.Kep., Ns., M.Kes Ns. Duma Lumban Tobing, M.Kep.,Sp.Kep.J. Abdul Rokhman, S.Kep., Ns., M.Kep…. selengkapnya
Rp 95.000 Rp 110.000JUDUL : MENTAL HEALTH NURSING (KEPERAWATAN KESEHATAN JIWA) PENULIS : Ns. Sri Nyumirah, M.Kep.,Sp.Kep.J Kens Napolion, S.Kp., M.Kep., Sp. Kep. J Basmalah Harun, S.Kep., M.Kes. Ns. Duma Lumban Tobing, M.Kep., Sp.Kep.J Ns. Sambodo Sriadi Pinilih, M.Kep., Sp.Kep.J Abdul Rokhman, S.Kep.,Ns.,M.Kep Siti Sholikhah, S. Kep., Ns., M.Kes. S. Dwi Sulisetyawati, S.Kep., Ns., M.Kep. Fifi Alviana, S.Kep.,… selengkapnya
Rp 130.000 Rp 150.000JUDUL :MONOGRAF PENYAKIT BUSUK BUAH KAKAO MALUKU UTARA KEPENGARANGAN Dr. Suratman Sudjud, SP., MP Layout & Desain Cover : Tim creative Rizmedia Ukuran unesco (15,5 x 23 cm ) Isbn : 978-623-8050-07-9 DESKRIPSI BUKU : Buku ini memuat secara spesifik penyakit busuk buah kakao yang ditulis dalam 8 (delapan) bab. Bab pertama berisi pendahuluan yang… selengkapnya
Rp 110.000 Rp 125.000JUDUL : INTERIOR RUMAH NUSANTARA KONTEMPORER PENULIS : Dr. Dra.Ika Yuni Purnama, M.Hum Dr. DJ.Dimas Phetorant, M.Pd Gelar Gelora Mestika, M.Pd HALAMAN : vi + 111 ISBN :978-(ON PROSES ) DESKRIPSI BUKU Melalui buku ini, kami ingin memperkenalkan konsep kearifan lokal yang dapat diintegrasikan dalam desain interior rumah modern, sehingga mampu mencerminkan identitas budaya… selengkapnya
Rp 60.000 Rp 75.000JUDUL : KEBUTUHAN DASAR MANUSIA (KDM) PENULIS : Ns. Hamidah Retno Wardani, S.Kep., M.Ked.Trop. Siti Nurhayati, S.Kep., Ns., M.Kep., Sp.Kep.An. Anissa Cindy Nurul Afni, S.Kep., Ns., M.Kep. Ns. Yanti Anggraini, S.Kep., M.Kep. Ns. Lusia Henny Mariati, M.Kep Ns. Donny Mahendra, S.Kep., M.Kep. Ns. Sri Melfa Damanik, M.Kep., Sp.Kep.An Ns. Seprinus Patoding, S.Kep., M.Kes, Atiek Murhayati,S.Kep.,… selengkapnya
Rp 118.000 Rp 130.000

Belum ada komentar, buka diskusi dengan komentar Anda.